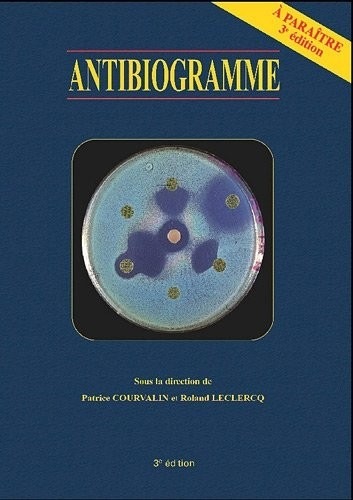
Antibiogramme 3e édition

Antibiogramme 3e édition
L'ouvrage « Antibiogramme » est la 3ème édition du livre paru en 1985. Cette nouvelle édition comporte de nombreux changements. Au cours des vingt années écoulées, de nouvelles classes d'antibiotiques ont été commercialisées et de nombreux caractères de résistance ont émergé et disséminé.
Il était donc amplement nécessaire de réactualiser un livre qui est à l'origine de la vulgarisation du concept de « lecture interprétative » des tests d'étude de sensibilité in vitro des bactéries aux antibiotiques.
L'ouvrage est structuré en quatre parties : les principes et les méthodes de l'antibiogramme, l'antibiogramme des principaux groupes bactériens, les fiches techniques d'étude pratique des antibiotiques et enfin des annexes et définitions. L'ouvrage, qui se veut pratique, est principalement destiné aux bactériologistes et biologistes hospitaliers, aux biologistes des laboratoires d'analyse médicale mais également aux infectiologues, réanimateurs, étudiants en médecine et aux professionnels de la Santé humaine et animale ou de l'industrie intéressés par l'antibiothérapie.